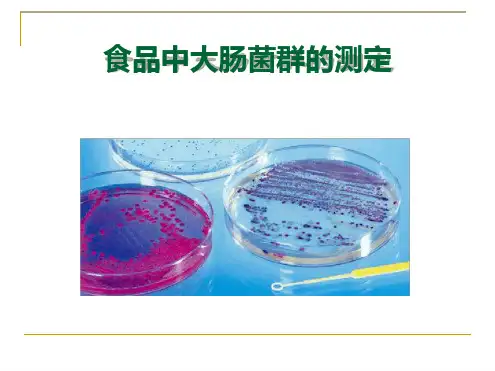

食品中大肠菌群测定(一)课件
- 格式:ppt
- 大小:1.64 MB
- 文档页数:61




实验--食品中大肠菌群的测定-课件 (一)随着人们对食品安全的重视,食品中大肠菌群的测定越来越受到关注和重视。
在食品安全监测和生产中,常常需要进行大肠菌群的检验,以保证食品的卫生安全。
此次实验旨在学习并掌握食品中大肠菌群的测定方法。
实验一、菌落计数法1.准备样品:取适量的食品样品,如牛奶、肉制品等,加入适量的蒸馏水,充分摇匀后待用。
2.制备平板:准备好平板培养基,常用的有菌落总数计数培养基和大肠杆菌计数培养基等。
用已灭菌的棉签挖取少量培养基涂抹在培养皿上,使其均匀分布。
3.采样:用无菌的移液管取一定量的稀释后的样品,滴于培养皿表面。
4.培养:将培养皿倒置放入恒温箱中,在37℃温度下培养24-48小时。
5.计数:观察培养皿上的菌落数量,使用菌落计数器进行计数,按一定倍数(如1/10、1/100)还原为真实菌落数量。
实验二、MPN法1.制备移液器:准备好10个稀释液和10个带有3个具孔的板,每个孔中加入相应的稀释液。
2.取样:从食品样品中取一定量,用蒸馏水稀释后,分别分装到板中。
3.培养:将板放到37℃恒温培养箱中进行培养,观察是否有生长。
4.判断仪器读数:根据板中生长、未生长的情况计算菌落数,并用最可能数法计算出MPN结果。
总结通过两种方法的比较,可以看出,两种方法都有各自的优点和缺点,需要根据实际需求进行选择。
对于无法进行菌落计数的样品,可以选择MPN法,它具有精度高、结果稳定等特点。
而对于数量较少的样品,可以更为准确地使用菌落计数法。
本次实验学习了食品中大肠菌群的测定方法,虽然实验中用了人工计数,但实际工作中,常常会结合现代化设备进行自动化检测,从而提高检测效率和准确度。
对于保障食品卫生安全,这一方面的控制是很有必要的。